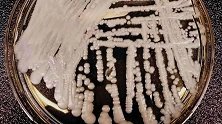
中国确诊18例超级真菌感染 致死率高达60%

关于“真菌”的视频
-
发布于:2021-06-20
-
发布于:2021-06-03
-
发布于:2021-04-24
-
发布于:2021-03-28
-
发布于:2021-03-11
-
发布于:2021-02-25
-
发布于:2020-11-30
-
发布于:2020-11-11
-
发布于:2020-11-08
-
发布于:2020-11-06
-
发布于:2020-08-03
-
发布于:2019-10-28
-
发布于:2019-09-01
-
发布于:2019-06-14